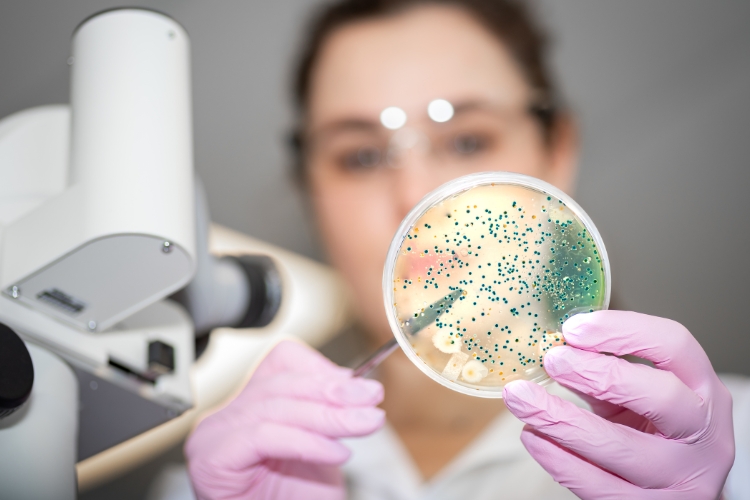

Складна екосистема з мільярдів мікроорганізмів, які живуть у травному тракті людини — це мікробіом кишківника. Саме він виконує важливі функції для підтримання здоров’я організму, впливаючи на травлення, імунітет, обмін речовин та навіть психічний стан. Порушення балансу мікрофлори може призвести до серйозних проблем зі здоров’ям.
Як проявляється дисбаланс мікрофлори кишківника
Дисбаланс мікрофлори кишківника (дисбіоз) проявляється через такі симптоми:
- Здуття, газоутворення, діарея чи закрепи.
- Хронічна втома та зниження енергії.
- Часті застуди через ослаблений імунітет.
- Погіршення стану шкіри (висипання, акне).
- Емоційна нестабільність, тривожність чи депресія.
Якщо ці симптоми тривають тривалий час, варто звернутися до лікаря та переглянути спосіб життя.
Пам’ятайте, що мікробіом кишківника виконує низку життєво важливих функцій. Зокрема, відповідає за травлення й засвоєння поживних речовин. Корисні бактерії допомагають розщеплювати складні вуглеводи, синтезувати вітаміни (зокрема групи В і К) та сприяти засвоєнню мінералів, таких як кальцій і магній. Майже 70 % імунних клітин організму знаходяться в кишківнику. Здорова мікрофлора стимулює вироблення антитіл і запобігає проникненню патогенних мікроорганізмів.
Як підтримувати здоровий мікробіом?
Насамперед допоможуть:
- Збалансоване харчування. Раціон повинен містити багато клітковини (овочі, фрукти, цільнозернові продукти), яка є живильним середовищем для корисних бактерій.
- Споживання пробіотиків і пребіотиків. Пробіотики (йогурт, кефір, ферментовані продукти) забезпечують організм корисними бактеріями. Пребіотики (часник, цибуля, банани) стимулюють їхній ріст.
- Обмеження цукру та обробленої їжі. Надмірне споживання цукру сприяє розмноженню шкідливих бактерій, які порушують баланс мікробіому.
- Контроль рівня стресу. Хронічний стрес негативно впливає на мікрофлору, тому важливо приділяти увагу релаксації та фізичній активності.
- Достатня кількість води. Вода сприяє підтриманню нормального травлення.
- Уникнення необґрунтованого прийому антибіотиків. Антибіотики знищують не лише шкідливі, а й корисні бактерії. Приймайте антибіотики строго за призначенням лікаря і в жодному разі не займайтеся самолікуванням. Після курсу антибіотиків важливо відновлювати мікрофлору за допомогою пробіотиків.
Як зауважують у медичному центрі Korona, здоровий мікробіом кишківника — це основа гарного самопочуття, міцного імунітету та здорового травлення. Підтримання балансу мікрофлори не потребує складних зусиль, але вимагає регулярності та свідомого підходу до способу життя.

Залишити коментар